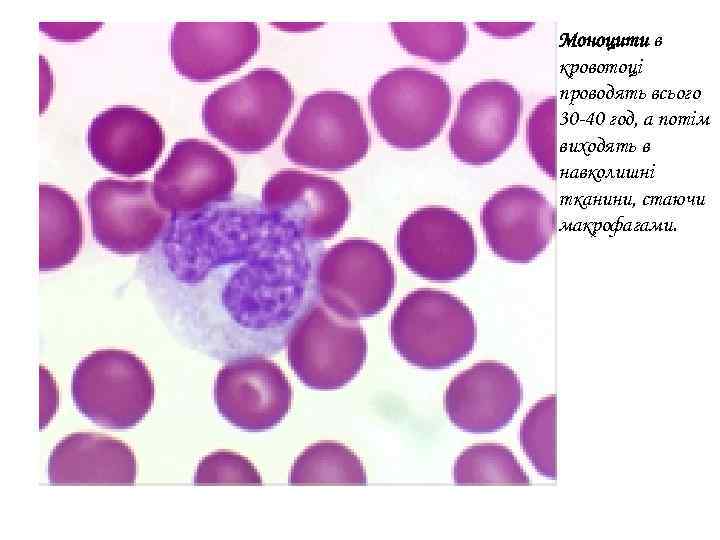
Моноцити в кровотоці проводять всього 30 -40 год, а потім виходять в навколишні тканини,

leykocyty_ta_jih_vydy.pptx
- Количество слайдов: 25




Нейтрофіли (Фагоцити) складають приблизно 70% від загальної килькості лейкоцитів. Нейтрофіли активно фагоцитують, тобто поглинають і перетравлюють, хвороботворні бактерії.

Еозинофіли відрізняються присутністю в цитоплазмі гранул, забарвлюються еозином в червоний колір. Еозинофіли володіють антигістамінніми властивостями. Вміст еозинофілів в крові регулюється гормонами, що секретується корою надниркових залоз у відповідь на найрізноманітніші стресові впливи.

Базофіли синтезують гепарин, білок, що перешкоджає згортанню крові, і гістамін, який ініціює зокрема запальну реакцію в пошкоджених тканинах, що сприяє їх швидкому загоєнню.
Моноцити в кровотоці проводять всього 30 -40 год, а потім виходять в навколишні тканини, стаючи макрофагами.

Макрофаги фагоцитують бактерії та інші відносно великі частки інфекції.

Лімфоцити індукують імунні реакції або беруть участь в них.

КЛАСИФІКАЦІЯ ІМУНІТЕТУ

+ натуральные киллеры + дендритные клетки 11


КЛАССИЧЕСКИЙ ПУТЬ АЛЬТЕРНАТИВНЫЙ ПУТЬ СИСТЕМА КОМПЛЕМЕНТА Комплексы антигенантитело * нейтрализация вирусов ** опсонизация воспалительные реакции, хемотаксис: запускаются а-фрагментами * литический комплекс ** Бактериальные мембраны и элементы клеточной стенки, факторы комплемента P, D, B Антитела и комплемент образуют на поверхности вируса слой, не позволяющий присоединяться к клетке-мишени ЛИЗИС Опсонизация: процесс присоединения веществ-опсонинов (иммуноглобулинов, элементов системы комплемента) к бактериям, в результате чего последние становятся более «заметными» для фагоцитов. 13



КОЛОНІАЛЬНА СЕЛЕКЦІЯ І ДИФЕРЕНЦІАЦІЯ В-ЛІМФОЦИТІВ



Клон может синтезировать антитела с одним и тем же паратопом, но с разными свойствами остальной части молекулы (т. е. относящееся к разным классам и выполняющее разные функции): Ig. G Ig. M Ig. A Ig. E Ig. D 19

Антиген х х Роль АП-клеток и Т-В кооперация АПК – антиген презентирующая клетка «предъявляет» антиген Т-хелперам Т-хелпер с соответствующим рецептором активируется, запускается его пролиферация Т-Вкооперация Деление Т-хелперы активируют В-лимфоциты, презентирующие сходные антигены Дифференцировка В-лимфоциты делятся, давая антител-образующие клетки (АОК) и В-клетки памяти (Вп) 20

АНТИГЕНПРЕЗЕНТУЮЧА ДЕНДРИТНА КЛІТИНА

Презентация антигена макрофагом АП-клетки. Общая схема расщепления антигена Презентация антигена дендритной клеткой класса II Клетка, осуществляющая захват антигена из внешней среды, расщепляет его, а затем «показывает» фрагменты на своей поверхности с помощью белков группы МНCII 22

MHCII – на антиген- презентирующих клетках (представление «чужих» антигенов Т-хелперам); взаимодействует с CD 4 Т-хелперов. MHCI – на всех клетках (представление «своих» антигенов Т-киллерам; появление «чужих» антигенов является признаком вирусной инфекции, онкологического заболевания, повреждения, старения клетки и т. п. ); взаимодействует с CD 8 Т-киллеров. 23

Клеточный иммунитет: макрофаги Макрофаги Тх1 Тхп ИЛ-3: рост и дифф-ка гемопоэтич. клеток ИЛ-4 ИЛ-10 Тх2 Тх, натур. киллеры Т-хелперы: дальнейший выбор пути Гуморальный иммунитет: антитела 24

(CD 4) Интерферон- ( «лейкоцитарный» ), интерферон- ( «фибробластный» ): действуют через общий рецептор, индуцируя синтез противовирусных белков, ингибирующих трансляцию Специфические препараты против вирусов – блокаторы обратной транскриптазы (СПИД) и других свойственных вирусам ферментов (например, нейраминидазы в случае гриппа) 25
leykocyty_ta_jih_vydy.pptx